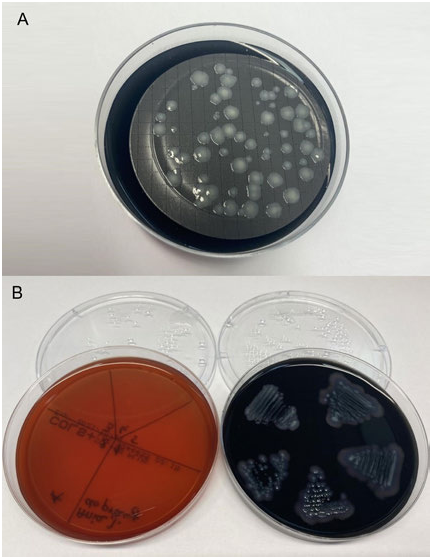
Gallery Image

Legionella spp
|
publication ID |
https://doi.org/10.24917/25438832.9.7 |
|
persistent identifier |
https://treatment.plazi.org/id/03CC8790-4460-FF8D-FF2E-6A720D7CFD19 |
|
treatment provided by |
Felipe |
|
scientific name |
Legionella spp |
| status |
|
Quantification of Legionella spp . bacteria
Water samples (100 ml) were filtered twice, and the filters were incubated on GVPC agar medium (VWR International, selective medium buffered with charcoal, yeast extract, glycine, vancomycin, polymyxin B and cyclohexamide) with acidic buffer (0.2 M HCl + 0.2 M KCl). The filter was washed with Ringer’s solution and then placed on GVPC agar medium and BCYE agar medium (VWR International, buffered agar medium with charcoal, yeast extract and cysteine). The plates were incubated at 36±2°C in a moist chamber. Reading was performed on the third, seventh and tenth days of incubation. A plate with presumed typical Legionella spp . colonies (white-grey colonies, smooth with a full rim with a characteristic ground glass appearance) ( Fig. 1A View Fig ) was inoculated onto BCYE and blood agar. On the tenth day, colony growth was assessed. A positive result was considered to be colonies growing on BCYE, and not growing on blood agar ( Fig. 1B View Fig ).
Identification of the major serogroups of Legionella spp . using the Legionella Latex Test
In order to identify Legionella pneumophila serogroup 1, Legionella pneumophila serogroup 2–14, and seven other most common pathogenic Legionella strains, a Legionella Latex Test (ThermoFisher Scientific, USA) was performed. A positive result was considered to be the appearance of agglutination in any of the fields with the test reagent within a maximum of 1 minute. A negative result was considered to be the absence of agglutination in all fields ( Fig. 2 View Fig ). Results
Frequency of occurrence of Legionella spp . in the tested swimming pool water
Water samples were taken from swimming pools and swimming pool equipment (swimming pool basin, showers, jacuzzi, circulating water, paddling pools, swimming pools) located at various facilities in Lesser Poland.
The number of confirmed Legionella spp . colonies was 75 occurrences out of 613 samples analysed during the period October – December 2021. The highest number of Legionella cases detected was in October, after which a decrease in positive results was observed in the following months ( Tab. 1).
A comparison of water samples taken from the pool and water pool equipment showed that in 48% of water samples Legionella spp . bacteria were detected in the swimming pool basin, 25% in the jacuzzi, 15% in circulating water, 7% in the shower tray, 2% in the men’s shower and 1% in the women’s shower ( Fig. 3 View Fig ).
No known copyright restrictions apply. See Agosti, D., Egloff, W., 2009. Taxonomic information exchange and copyright: the Plazi approach. BMC Research Notes 2009, 2:53 for further explanation.
|
Kingdom |
|
|
Phylum |
|
|
Class |
|
|
Order |
|
|
Family |
|
|
Genus |